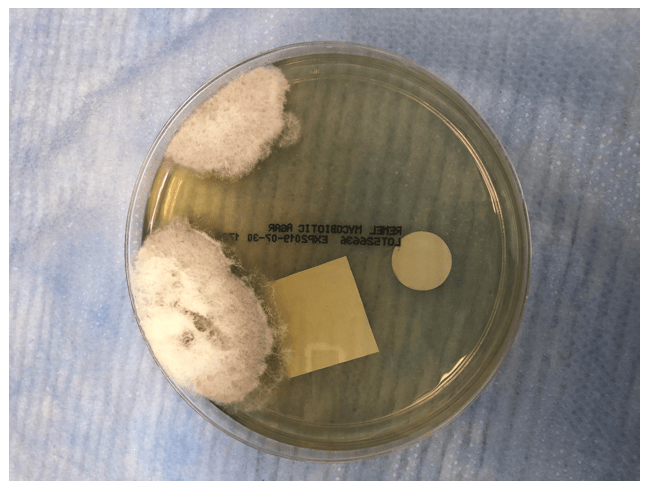

Clinical history
A 62 year old woman from the state of Vermont with a past medical history of anxiety, depression, and granulomatous dermatitis presented to her primary care physician for bilateral Achilles tendonitis, bilateral knee effusion, and bilateral conjunctivitis; all of which were self-limited. Additional laboratory work-up from the encounter revealed an incidental 7mm right medial lung nodule with associated unilateral hilar lymphadenopathy. The patient denied any history of using tobacco products but had a remote travel history to Arizona and seasonally visited California. An endobronchial ultrasound guided fine needle aspiration was performed and the on-site evaluation showed abundant necrosis with scattered refractile objects consistent with fungal organisms. Additional tissue was submitted for cytology and fungal cultures.
Laboratory identification
Initial review of the cytology revealed abundant alveolar macrophages and inflammatory cells in a background of necrotic debris. The modified gomori methenamine-silver nitrate(GMS) stain highlighted several variably sized 8-15um broad-based budding yeast with a double contour cell wall (Image 1). Secondary review of the slides showed additional rare large 50-70um thick-walled spherules with 2-4um endospores (Image 2). Following 10 days of incubation there was growth of a fluffy white colony of mold on both the potato flake and mycosel agar plates (Images 3-4). The lactophenol cotton blue adhesive tape preparation highlighted large thick-walled barrel shaped arthroconidia with alternating empty cells (Image 5). A nucleic acid probe definitively identified the organism as Coccidiodes posadasii/immitis.

Discussion
Coccidiodes immitis is a dimorphic fungus commonly found in the Southwestern United States and Central/South America. Immunocompetent patients can develop a self-limited acute pneumonia (Valley Fever) and the diagnosis is frequently under recognized. Immunocompromised patients however, such as those with acquired immunodeficiency syndrome (AIDS) can develop systemic disease with fungal dissemination to the bones, lungs, and skin (1). The estimated risk of exposure in endemic regions is approximately 3% per year with the greatest risk occurring during the dry season (5). Infection typically begins with inhalation of the arthroconidia which then mature in the lungs from barrel shaped cells to enlarging spherules up to 80um in diameter. Mature spherules consist of internal septations with 2-4um endospores which subsequently rupture releasing endospores into infected tissues which can mimic Histoplasma. When large round yeast forms are observed in tissue it is important to maintain a broad differential diagnosis which includes Coccidioides, Blastomyces, Paracoccidioides and in some instances Candida species. Although 8-15um broad-based budding yeast lacking endospores are typically associated with Blastomyces this can also represent germinating Coccidiodes endospores. Within the literature there are case reports describing Coccidioidomycosis infections with unusual in vivo morphologic forms consisting of juxtaposed immature spherules without endospores and germinating endospores (2). These elements on microscopic examination can easily be mistaken for budding cells of Blastomyces. Furthermore Blastomyces can rarely exhibit “giant” multinucleated yeast cells, mimicking Coccidioides (3). Therefore, as highlighted by our case for accurate differentiation of these two fungi correlation of the patients travel history, fungal cultures, and cytology is recommended.
In the case of our patient, although she was a resident of Vermont, a growing endemic hotspot for Blastomyces infections, she had additional travel history to Arizona and California increasing her risk for infection with Coccidiodes. Furthermore her urine antigen test for Blastomyces was negative and her fungal culture only grew Coccidiodes as confirmed by the lactophenol cotton blue preparation and nucleic acid probe. In addition, Blastomyces typically take several weeks longer than Coccidiodes to grow on culture and microscopically present with septate hyphae with short or long conidiophores with pear-shaped conidia at the tips of conidiophores (lollipops). Collectively her clinical history and laboratory work up was most suggestive of a Coccidioidomycosis. Although rare and less likely, it is also possible that she may have had a remote or concurrent Blastomyces infection which was unable to grow on culture and could not be definitively excluded.
Typically for immunocompetent hosts, asymptomatic Coccidioidomycosis (Valley fever) infections do not need require treatment. However in the context of this patient’s history of dermatologic and rheumatologic complaints, her systemic course warranted treatment with 6 months of itraconazole (4). Of note, itraconazole is also the treatment of choice for Blastomyces infection but would require a shorter 3 months duration of treatment.
References
- Saubolle MA, Mckellar PP, Sussland D. Epidemiologic, clinical, and diagnostic aspects of coccidioidomycosis. J Clin Microbiol. 2007;45(1):26-30.
- Kaufman L, Valero G, Padhye AA. Misleading manifestations of Coccidioides immitis in vivo. J Clin Microbiol. 1998;36(12):3721-3.
- Wu SJ, Valyi-nagy T, Engelhard HH, Do MA, Janda WM. Secondary intracerebral blastomycosis with giant yeast forms. Mycopathologia. 2005;160(3):253-7.
- Monaco WE, Batsis JA. A case of disseminated blastomycosis in Vermont. Diagn Microbiol Infect Dis. 2013;75(4):423-5.
- Dodge RR, Lebowitz MD, Barbee R, Burrows B. Estimates of C. immitis infection by skin test reactivity in an endemic community. Am J Public Health. 1985;75(8):863-5.
-Noman Javed, MD is a 3rd year anatomic and clinical pathology resident at the University of Vermont Medical Center.

-Christi Wojewoda, MD, is the Director of Clinical Microbiology at the University of Vermont Medical Center and an Associate Professor at the University of Vermont.
Very interesting report. Thank you. 50 yrs ago while working in a small hospital I encounter COCCI. From bronch washing, given heads-up on what I would find. Without a hood, when fuzzy growth developed at 5-7 days, I burned a tiny hole in plate lid (very taped plate), injected mineral oil, aspirate some oil back, to slide and found arthrospores as expected. Now would send to reference lab! I live in Southern Ca.